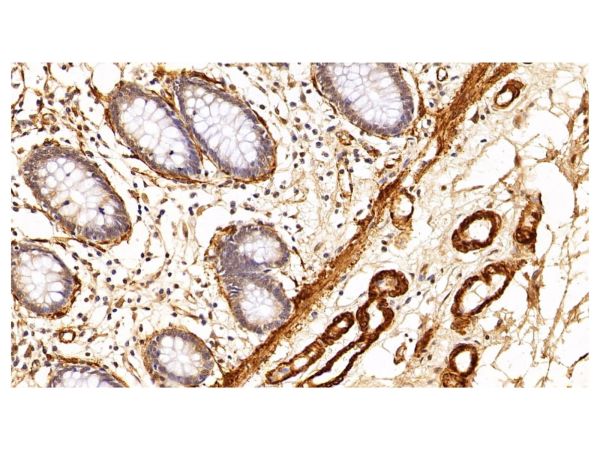
aladdin 阿拉丁 Ab088443 alpha-Smooth Muscle Actin Mouse mAb mAb (F1); Mouse anti Human alpha-Smooth Muscle Actin Antibody; WB, IHC; Unconjugated

网站主页
ALPHA-SMOOTH MUSCLE ACTIN MOUSE MAB
alpha-Smooth Muscle Actin Mouse mAb
aladdin 阿拉丁 Ab088443 alpha-Smooth Muscle Actin Mouse mAb mAb (F1); Mouse anti Human alpha-Smooth Muscle Actin Antibody; WB, IHC; Unconjugated
alpha-Smooth Muscle Actin Mouse mAb
¥499.90
10μl
起订
¥1299.90
50μl
起订
¥2099.90
100μl
起订
上海 更新日期:2025-05-16
产品详情:
- 中文名称:
- alpha-Smooth Muscle Actin Mouse mAb
- 英文名称:
- alpha-Smooth Muscle Actin Mouse mAb
- 品牌:
- 阿拉丁
- 产地:
- 上海
- 保存条件:
- -20°C储存,避免反复冻融
- 纯度规格:
- 无载体, ExactAb™, 已验证, 高性能, 见COA
- 产品类别:
- 抗体 单克隆抗体
- 分子式:
- C60H103N2O13S4
- 分子量:
- 1286.75
- 运输条件:
- 超低温运输
- 产品规格:
- 100μl、50μl、10μl
- 货号:
- Ab088443
- 是否进口:
- 否
公司简介
上海阿拉丁生化科技股份有限公司是A股上市公司((股票代码:688179),专注于科研试剂的研发、生产和销售,已陆续建立多个工厂和研发中心。作为领军企业,阿拉丁始终坚持质量第一,连续13年被评为“最受欢迎试剂品牌”。
阿拉丁目前常备库存试剂产品品种超过7万种,SKU总数超过46万,产品线涵盖了化学试剂、生化试剂、药靶配体、蛋白质和抗体等多个领域,是国内少数化学试剂到生物试剂全面发展的国产试剂品牌,产品同步发布在我们国内外电商平台。
| 成立日期 | (18年) |
| 注册资本 | 14130.676万人民币 |
| 员工人数 | 500人以上 |
| 年营业额 | ¥ 1亿以上 |
| 经营模式 | 工厂,试剂 |
| 主营行业 | 生物化工,化学试剂 |
alpha-Smooth Muscle Actin Mouse mAb相关厂家报价
-

- 肌动蛋白α/α-SMA/α Actin单
- 上海抚生实业有限公司 VIP
- 2026-04-17
- ¥1180
-

- 肌动蛋白α/α-SMA/α Actin单克隆抗体
- 上海博湖生物科技有限公司 VIP
- 2026-04-17
- ¥1180
-

- 肌动蛋白α/α-SMA/α Actin单克隆抗体
- 上海西格生物科技有限公司 VIP
- 2026-04-17
- ¥1180

>
>
 >
>
 >
>
 >
>
 >
>
 >
>
 >
>
 >
>



